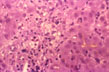

Cholestasis is stagnation of bile due to impairment of bile flow along its outflow tract leading to accumulation of bile components in the blood. The two major componenets of bile are bilirubin and bile acids. Retention of bilirubin (BILIRUBINOSTASIS) produces jaundice and presence of bilirubin pigment9n hepatocytes, bile canaliculi and bile ducts. Retention of bile acids produces pruritus and typical changes in the periportal region of the liver which goes under the name of CHOLATE STASIS
|
BILIRUBINOSTASIS
- CYTOPLASMIC CHOLESTASIS: Presence of bile in form of fine yellow pigment throughout the cytoplasm of hepatocytes, not in lysosomes which have pericanalicular distribution. Bile stained with Hall's method will be green.
- CANALICULAR CHOLESTASIS: Presence of bile thrombi in bile canaliculi. In mild cases they are seen in the central lobular zone; in severe cases they are seen in the mid and peripheral zone.
- DUCTULAR CHOLESTASIS: Stagnation of bile in periportal bile ductules (ducts of Hering) which are increased in number and are dilated. It is observed in severe biliary obstruction, severe necrotizing hepatitis (Schmid, Human Path. 3:19,1972) and in septicaemia (Lefkowitch, Human Path. 13:19 1982)..
- DUCTAL CHOLESTASIS: Presence of bile casts in portal bile ducts. It is rarely seen.
|
CHOLATE STASIS
|
Is a term indicating peculiar changes in periportal hepatocytes and attributed to stagnation of bile acids (Popper H, Hepathology, 1:187, 1981). The changes consist of hydropic swelling of hepatocytes with clearing of their cytoplasm and concentration of the remaining cytoplasm in the perinuclear region where it may form Mallory bodies. The process is accompanied with accumulation of copper-binding protein in autophagic vacuoles which can be stained with orcein (Salaspuro et al, Scand.J. Gastroenter., 11:677-682, 1976) or with specific antibodies (Janssens et al, Liver 4:139-147, 1984) together with copper granules that can be visualized with rhodamine stain. The protein was identified as metallothionein (Janssens 1984, ibid.). The changes are attributed to the detergent effect of retained bile acids. It is observed in extrahepatic biliary obstruction and primary cholestasis such as PBC (primary biliary cirrhosis) and PSC (primary sclerosing cholangitis).
|
|
Cytoplasmic cholestasis
|
Fig 49 - CYTOPLASMIC CHOLESTASIS: Presence of yellow pigment throughout the cytoplasm and not in lysosomes which are pericanalicular. Bilirubin granules will stain green with Hall's method. The hepatocytes may show Mallory bodies, eosinophilicand pseudoxanthomatous degeneration. There may be foci of cell dropout. These changes are most prominent in the central lobular area.
|
|
"Canalicular cholestasis"
|
Fig 50 - CANALICULAR CHOLESTASIS: There are bile thrombi in bile canaliculi, in the central lobular zone in ml cases and in the peripheral zone in severe cases. Hepatocyte damage, bile lakes and bile infarcts may also occur. This sample is from a case of acute cholestatic hepatitis A. |
|
Ductular cholestasis
|
Fig 51 - DUCTULAR CHOLESTASIS: Periportal bile ductules are hyperplastic, dilated and contain bile stained concrements. The interlobular bile duct is free. This sample is from a case of fungal sepsis following bone marrow transplant. |
|
Cholate stasis
|
Fig 52 - CHOLATE STASIS: The periportal hepatocytes are swollen, hydropic and foamy, pseudoxanthomatous cells. These are the changes of so-called "biliary piece meal necrosis" that occurs in stagnation of bile flow. The changes are attributed to retention of bile acids. This sample is from a case of primary biliary cirrhosis (PBC). |